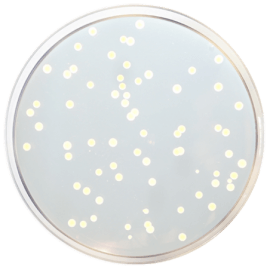
main product photo

Close
TRYPTICASEIN SOY AGAR (T.S.A.) (Eur. Pharma.) 500 grams/bottle
SKU
CDL/1068
Brand
CONDALAB
Pre-order (Deliver in 8 to 12 weeks)
Trypticasein Soy Agar (TSA) is a general purpose medium very rich in nutrients for general use in microbiological laboratories and for the cultivation and isolation of fastidious or non fastidious microorganisms, or for the maintenance of stock culture. It supports the abundant growth of fastidious organisms such as pneumococci, streptococci, Neisseria, etc. from clinical samples.
Containing two peptones as rich nitrogen sources, obtained by the enzymatic hydrolysis of casein and soy proteins, this medium supports the growth of a great variety of microorganisms, including fastidious aerobes and anaerobes. Soy peptone also contains natural sugars which promote bacterial growth. Sodium chloride supplies essential electrolytes for transport and osmotic balance. Bacteriological agar is the solidifying agent.
Since it lacks carbohydrates it is very useful in the study of hemolytic reactions and also in the preparation of chocolate agar.
If desired, antibiotics can easily be incorporated as well as other supplements or inhibitory agents.
Some of the microorganisms that grow on this medium are the following: Streptococcus, Neisseria, Brucella, Corynebacteria, Listeria, Pasteurella, Vibrio, Haemophilus vaginalis, Candida, etc.
The European Pharmacopoeia, USP recommends this medium in the paragraph 2.6.12: Microbiological examination of non sterile products: Microbial enumeration test for the examination of TAMC and TYMC in products.
The ISO 11133 Norm recommends the Trypticasein Soy Agar (TSA) as a reference medium.
Trypticasein Soy Agar (TSA) is a general purpose medium very rich in nutrients for general use in microbiological laboratories and for the cultivation and isolation of fastidious or non fastidious microorganisms, or for the maintenance of stock culture. It supports the abundant growth of fastidious organisms such as pneumococci, streptococci, Neisseria, etc. from clinical samples.
Containing two peptones as rich nitrogen sources, obtained by the enzymatic hydrolysis of casein and soy proteins, this medium supports the growth of a great variety of microorganisms, including fastidious aerobes and anaerobes. Soy peptone also contains natural sugars which promote bacterial growth. Sodium chloride supplies essential electrolytes for transport and osmotic balance. Bacteriological agar is the solidifying agent.
Since it lacks carbohydrates it is very useful in the study of hemolytic reactions and also in the preparation of chocolate agar.
If desired, antibiotics can easily be incorporated as well as other supplements or inhibitory agents.
Some of the microorganisms that grow on this medium are the following: Streptococcus, Neisseria, Brucella, Corynebacteria, Listeria, Pasteurella, Vibrio, Haemophilus vaginalis, Candida, etc.
The European Pharmacopoeia, USP recommends this medium in the paragraph 2.6.12: Microbiological examination of non sterile products: Microbial enumeration test for the examination of TAMC and TYMC in products.
The ISO 11133 Norm recommends the Trypticasein Soy Agar (TSA) as a reference medium.
| Brand | CONDALAB |
|---|
Write Your Own Review

Validate your login